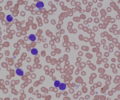

Welcome to LabIQ! An interactive learning experience prepared by Laboratory Medicine and Molecular Diagnostics staff. Time spent on Lab IQ may be counted as a professional development activity for the CMLTO Professional Portfolio.
Case 1 January 27, 2020 - An 80 year old male with a history of lymphocytosis, weight loss, fatigue and lymphadenopathy presents to hospital.
Case 1 January 27, 2020 - An 80 year old male with a history of lymphocytosis, weight loss, fatigue and lymphadenopathy presents to hospital.